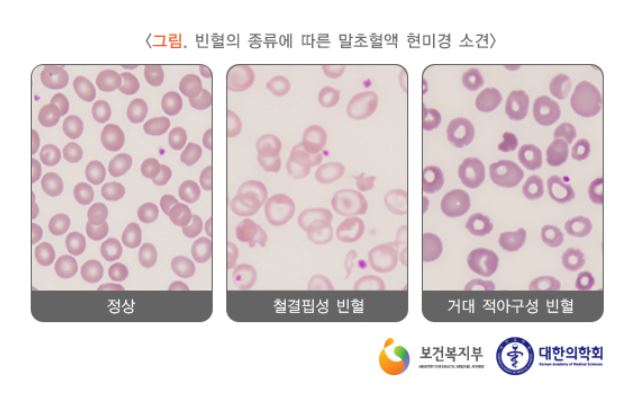

MCHC 수치와 임상적 의의
오늘은 CBC 검사 중 하나인 'MCHC' 검사의 수치와 임상적 의의에 대해서 알아보도록 하겠습니다. MCHC는 'Mean corpuscular hemoglobin concentration'의 약자로 평균 적혈구 헤모글로빈 농도로 번역할 수 있습니다. 즉, 적혈구 내에 헤모글로빈(Hb)이라는 성분이 어느 정도 농도로 포함되어 있는지를 수치화해서 나타내는 검사결과인 것이죠.

헤모글로빈(Hb)은 적혈구의 단백질로써 폐에서 몸의 다른 부위와 장기로 산소를 운반하는 역할을 맡고 있습니다. 이러한 헤모글로빈의 농도가 높고 낮음에 따라서 여러가지 임상적 의의를 가질 수 있기에 해당 수치를 파악하고 환자의 진단에 이용하고 있습니다. MCHC수치와 함께 MCV, RDW 수치 등 여러 가지 수치를 종합적으로 평가해 환자의 질환을 구분하고 적절한 치료 방안을 선택할 수 있습니다. MCV, RDW 수치와 관련해서는 아래 글에 자세하게 적어두었으니 참고하시기 바랍니다.
2023.02.10 - [혈액검사/혈구 검사] - RDW 수치와 임상적 의의
RDW 수치와 임상적 의의
오늘은 CBC 검사를 수행하게 되면 나오는 계산식 중 하나인 RDW 수치에 대해서 알아보도록 하겠습니다. RDW는 'Red blood cell Distribution Width'의 줄임말로써 적혈구 크기의 분포가 어떠한지를 나타내는
normalvalue.tistory.com
2020.05.01 - [혈액검사/혈구 검사] - MCV 수치의 임상적의의
MCV 수치의 임상적의의
오늘은 CBC 검사 중 하나인 MCV 수치에 대해서 조금 자세히 알아보도록 하겠습니다. CBC(전혈구검사)를 진행하게 되면 RDW, MPV, MCV, MCH 등 다양한 계산값들이 존재합니다. 여기서 오늘 알아볼 MCV는 Mea
normalvalue.tistory.com
MCHC의 정상수치는?
정상적인 MCHC의 수치는 대략 32-36g/dL로 알려져 있습니다. 하지만 해당 정상수치는 병원마다, 사용하는 장비마다 상이할 수 있으니 꼭 병원에서 제시하는 참고치를 기반으로 해석하시기 바랍니다. 정상수치를 벗어난 경우에는 수치에 따라 그리고 다른 검사결과의 종합적 판단에 따라 주로 용혈성 빈혈, 철 결핍성 빈혈, 지중해성 빈혈, 겸상 적혈구 빈혈 등 다양하게 분류할 수 있습니다.
적혈구 내에 헤모글로빈(Hb) 수치가 증가하여 MCHC 수치가 증가하게 되면 적혈구의 경직성이 증가하여 적혈구의 수명과 산소 운반 능력에 크게 영향을 미칠 수 있습니다. 반대로 헤모글로빈(Hb) 수치가 낮아져 적혈구 내에 헤모글로빈이 모자라게 되면 위에 설명드린 것처럼 우리 몸 구석구석 필요한 만큼 산소 전달이 이루어지지 않기 때문에 빈혈의 위험도가 증가하게 됩니다.

보통 MCHC가 정상 범위 내에 있다면 Normochromic 하다고 표현하며 MCHC 수치가 증가한 경우 'Hyper'chromic 하다. 반대로 MCHC 수치가 낮은 경우 'Hypo'chromic하다고 표현합니다. 하지만 MCHC 수치는 CBC 검사의 한 부분일 뿐이며, 다른 CBC 지표 및 화학 검사와 함께 종합적인 평가가 이루어져야 합니다. 만일 MCHC 수치가 비정상인 경우 진료를 받고 의료진과 협력하여 근본 원인을 진단하고 치료 계획을 수립하는 것이 중요합니다. 치료 방식은 MCHC 수치의 근본적인 원인에 따라 달라지며 생활 습관 및 식습관, 약물 치료가 병행될 수 있습니다.
MCHC 수치를 증가시키기 위한 생활 및 식습관
대한민국에서 대부분의 경우 빈혈로 인한 MCHC 수치 저하를 가진 환자가 대부분이기에 생활 및 식습관을 통해 MCHC 수치를 증가시키는 방법을 몇가지 공유하도록 하겠습니다.
| ● 균형 잡힌 식단 (과일, 채소, 저지방 유제품, 저지방 단백질, 통곡물 등) ● 충분한 수분 섭취 (탈수증은 MCHC 수치를 낮출 수 있음) ● 알코올 섭취 제한 (알코올은 MCHC 수치에 부정적 영향을 줌) ● 철분이 풍부한 식품 섭취 (철분은 헤모글로빈의 핵심 성분) ● 건강에 해로운 지방 피하기 (트랜스 지방, 포화 지방) |
내용이 도움이 되셨거나 초보 블로거를 응원하고 싶으신 분은 아래 하트♥공감 버튼을 꾹 눌러주세요!
궁금하신 사항이 있으시다면 댓글을 남겨주세요!
*쿠팡파트너스 활동으로 일정 수수료를 지급받을 수 있으나, 구매 고객에게 추가금액이 발생하지는 않습니다.
'혈액검사 > 혈구 검사' 카테고리의 다른 글
| MPV(Mean Platelet Volume) 수치와 임상적 의의 (0) | 2023.04.03 |
|---|---|
| PDW(Platelet Distribution Width) 수치와 임상적 의의 (0) | 2023.04.02 |
| RDW 수치와 임상적 의의 (0) | 2023.02.10 |
| 비타민D(Vitamin D) 수치와 임상적 의의 (0) | 2020.10.05 |
| 프로트롬빈시간(PT,INR) 수치와 임상적 의의 (1) | 2020.09.23 |







